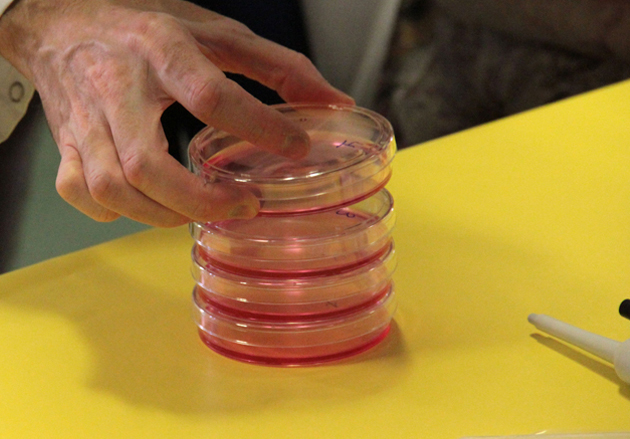

La Fundació Catalana per a la Recerca i la Innovació (FCRi) participa com a soci a l’Estat espanyol, en el programa europeu Path2Integrity, de tres anys de durada i que té com a objectiu millorar la integritat de la recerca científica. La iniciativa, finançada per la Unió Europea dins el Programa Marc Horitzó 2020, vol fomentar una cultura de la coneguda com Research Integrity (RI), mitjançant una campanya divulgativa adreçada a alumnes de secundària i batxillerat, universitaris, doctorands i doctors, a banda de produir continguts educatius innovadors i crear formadors experts en la matèria.
Liderat per la Universitat de Coburg (Alemanya), el programa compta amb 8 socis de 5 països europeus: Alemanya, Espanya, Dinamarca, Bulgària i Polònia. Path2Integrity vol establir metodologies innovadores de capacitació en RI, un concepte basat en el compromís dels investigadors amb l’honestedat intel·lectual, la responsabilitat personal i l’adhesió a regles i pautes comunament acceptades pels codis professionals, com ara The European Code of Conduct for Research, elaborat per la European Federation of Academies of Science and Humanities (ALLEA).
Per a la UE, l’RI exerceix un paper fonamental per a salvaguardar la confiança de la societat en al recerca científica i, alhora, convertir-la en més fiable, eficient i útil per a la població. Tot això en un context marcat per avenços científics espectaculars en àmbits com ara la biotecnologia, la nanotecnologia o les tecnologies de la informació. Aquest projecte s’emmarca en la consideració actual, per part de la UE de la ciència, la tecnologia i la innovació com una de les vies més prometedores per a la creació de feina i per millorar la qualitat de vida.
A banda de l’FCRi i la Universitat de Coburgo (Alemanya), la resta de socis són la Universitat de Syddansk (Dinamarca); 3C Compliance (España); Pensoft Publishers (Bulgària); EUREC office gUC i la Universitat Christian-Albechts de Kiel (Alemanya); i l’Institut Badaṅ Edukacyjnych (Polònia).
*Aquest projecte és finançat pel programa de la UE Horitzó 2020 amb l’acord de consorci No. 824488.
Notícies
L’FCRi participa al projecte europeu Path2Integrity, destinat a millorar la integritat de la recerca científica